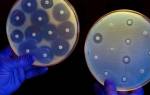
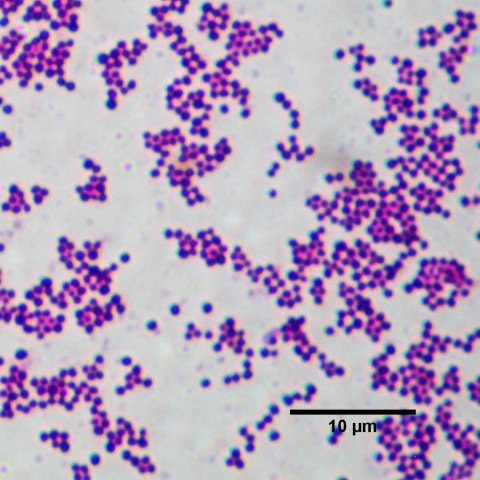

Стафилококк считается одним из нормальных микроорганизмов человека, который обитает на коже и слизистых. При этом он может быть очень коварен – как только иммунитет снизится, нормальная микрофлора становится причиной гнойных воспалительных заболеваний.
Причины появления стафилококка в зеве
Наличие стафилококка в зеве провоцирует развитие инфекционного воспалительного процесса в нем
Стафилококк составляет основу нормальной микрофлоры человеческого организма. Этот микроорганизм обитает на коже, части слизистых, на окружающих предметах и в воздухе. Он считается самым распространенным микробом, обитающим рядом с человеком. При этом он относится к условно-патогенным бактериям.
Для здорового человека с развитым иммунитетом, соблюдающего правила личной гигиены, большинство разновидностей стафилококка совершенно безвредны. Опасным этот микроб становится в тех случаях, когда на кожу или слизистую попадает большое количество бактерий одновременно (при контакте с больным или пренебрежении личной гигиеной), стафилококк оказывается на травмированном участке кожи или слизистой, а также если снижается местный или общий иммунитет. В этом случае развиваются гнойные инфекции.
В зеве обитает небольшое количество стафилококка, который попадает туда, мигрируя с кожи, проникает с пищей и с различных предметов, с которыми контактирует человек.
В норме это не несет никакой угрозы для здоровья. У большинства людей стафилококк обнаруживается в зеве постоянно. Возможно заражение стафилококком – чаще всего это происходит воздушно-капельным путем при контакте с человеком, который болеет стафилококковыми воспалительными процессами в зеве.
В этот момент в организм здорового человека поступает большая заражающая доза. Но для развития болезни необходимо сочетание нескольких факторов – например, заражение и переохлаждение или уже идущий вирусный воспалительный процесс (простуда или грипп).
Основные симптомы и возможные осложнения
Боль в горле и высокая температур — признаки инфекции
Само по себе наличие стафилококка не проявляется никакими симптомами – это нормальная микрофлора, которая без вреда сосуществует со здоровыми людьми. Симптомы возникают в том случае, когда возникает патологический процесс.
Среди болезней зева, которые вызывает стафилококк:
- Гнойная ангина.
- Гнойный фарингит.
- Абсцесс миндалины.
- Флегмона.
Эти заболевания обладают рядом общих симптомов – у пациента резко поднимается температура тела, ухудшается самочувствие, появляется сильная головная боль, утомляемость. Возникает слабость, пациент не может выполнять ни физическую, ни умственную работу – работоспособность заметно снижена.
Несколько позже появляются местные признаки инфекции – покраснение горла, появление гнойного налета на миндалинах и задней стенке глотки, боли в горле – при глотании, разговоре и в покое. Появляется кашель, увеличиваются лимфоузлы на шее и за ушами.
В детском возрасте заболевание развивается стремительно, высокая температура сопровождается риском обезвоживания.
Если ребенок посещает детский сад, школу или кружок, то появление одного инфицированного малыша грозит массовой вспышкой заболеваний. При заражении у разных пациентов могут возникнуть разные виды болезней – это зависит от того, где именно стафилококк найдет для себя подходящие условия.
Осложнения болезни, которые возникают, если ее не лечить, связаны в основном с тем, что бактериальная инфекция имеет тенденцию к распространению – воспалительный процесс охватывает все большую и большую площадь. Из зева стафилококк распространяется в среднее ухо, гортань, ближайшие лимфатические узлы, а также в клетчатку, окружающую глотку и пищевод. Наиболее тяжелое осложнение – сепсис.
Другая группа осложнений – аутоиммунные. Поверхностные антигены стафилококка похожи на антигены соединительной ткани человека, и длительное течение стафилококковой инфекции приводит к ревматическому поражению суставов и сердца.
Способы диагностики инфекции
Результаты мазка помогут подтвердить или опровергнуть наличие бактерии
Наиболее точный метод диагностики – обнаружение стафилококка в отделяемом из ротоглотки. Для анализа берется мазок со слизистой или мокрота, выделяемая при кашле. Затем она помещается на питательную среду, где вырастают колонии бактерий.
Стафилококк растет относительно быстро – это около 3 дней. Обнаруженные колонии исследуют под микроскопом и обнаруживают в них бактерию. Такой метод наиболее точен, но его проведение требует времени. Обычно лечение назначают не дожидаясь результатов данного анализа, они выступают как подтверждение или опровержение правильности выбранной тактики.
Бактериологическое исследование обычно сочетают с антибиотикограммой – исследованием, показывающим чувствительность к определенным видам антибиотиков. Это важно, поскольку стафилококк достаточно быстро приспосабливается к методам борьбы с ним, вырабатывает устойчивость к антибиотикам.
Материалом для анализа выступает кровь из вены. Метод основан на обнаружении антител к бактериям. Он подтверждает, что причиной болезни является именно стафилококк, а не другой микроорганизм, а также выявляет его в течение суток. Дополнительно проводятся и другие анализы – биохимия крови, анализ мочи, которые показывают общее состояние организма. Возможно, будет назначено обследование на ревматический фактор, чтобы вовремя выявить и начать лечить ревматизм.
Медикаментозные препараты от стафилококка
Лечение комплексное, включая прием антибиотиков
Наиболее эффективный способ вылечить стафилококк в зеве – антибактериальная терапия. Только антибиотики могут устранить болезнетворный микроорганизм, снизить количество бактерий и вылечить болезнь.
Но основная проблема антибиотикотерапии стафилококковых инфекций состоит в том, что самый распространенный микроорганизм легко вырабатывает устойчивость к антибактериальным препаратам. Например, когда был открыт пенициллин, он был очень действенным препаратом против стафилококка, помогал большинству пациентов.
На сегодняшний день до 90% штаммов стафилококка устойчиво к пенициллину (PRSA). Для борьбы с ними были изобретены новые антибиотики, к которым также развилась устойчивость, сформировались штаммы MRSA (метициллин-резистентный стафилококк) и WRSA (ванкомицин-резистентный, в основном представляющий больничную микрофлору). Поэтому в случае стафилококковой инфекции тест на чувствительность к антибиотикам обязателен.
Для лечения стафилококковых инфекций в горле применяются следующие препараты:
- Амоксиклав
- Ципрофлоксацин
- Левофлоксацин
- Цефалексин
- Ванкомицин
Эти препараты назначают в таблетках. Необходимо строго соблюдать инструкцию по применению и предписания врача. В тяжелых случаях их могут назначить в виде внутримышечных инъекций. Как правило, курс лечения начинают до получения результатов анализа. По результатам антибиотикограммы препарат меняют или продолжают его прием.
В том случае, когда антибиотики противопоказаны, назначают стафилококковый бактериофаг. Это безвредный для человека вирус, который уничтожает бактерии. Препарат достаточно дорогой, но подходит для лечения маленьких детей и кормящих матерей.
Широко используются патогенетические (противовоспалительные, откашливающие), иммуностимулирующие и симптоматические средства, но они эффективны только при одновременном приеме с антибиотиками.
Лучшие народные методы и рецепты
Полоскание горла поможет быстрее вылечить инфекционное заболевание
Народное лечение в основном основано на симптоматической терапии. Оно ни в коем случае не заменяет лечение с помощью медицинских препаратов. Тем не менее, ряд народных методов может оказаться полезным и улучшить самочувствие.
Самая распространенная рекомендация – полоскание горла различными настоями. Этот метод можно применять практически у любых пациентов, кроме маленьких детей и лежачих пациентов, которые могут подавиться.
Для полоскания подходят растворы соли и соды, настои лекарственных трав – календулы, ромашки, эвкалипта и других. Также можно использовать разбавленные спиртовые настойки тех же растений.
Для укрепления иммунитета, советуют употреблять в пищу лук, чеснок, малину и красную смородину. Листья малины и смородины можно заваривать вместе с чаем. Хороший эффект дают ножные ванночки с горячей водой, прогревающие процедуры.
Для того, чтобы не заразиться стафилококком, необходимо избегать контактов с больными людьми, соблюдать правила личной гигиены и укреплять иммунитет. Тем не менее, полностью исключить контакт с бактериями невозможно, поэтому наиболее важными становятся именно меры по укреплению иммунитета.
Больше информации о золотистом стафилококке можно узнать из видео:
Staphylococcus aureus (стафилококк ауреус, золотистый стафилококк) — условно-патогенная бактерия, обитающая на различных объектах окружающей среды и в локусах человеческого организма. Микробы колонизируют кожный покров и слизистую оболочку внутренних органов. Их обнаруживают в воздухе, почве, на бытовых предметах, игрушках, медицинских инструментах. Условно-допустимое количество золотистого стафилококка в любом биоматериале – менее 10 4 колониеобразующих единиц. Заразиться этой опасной инфекцией можно в местах общего пользования.
Микроб получил свое название благодаря свечению золотистого цвета, которое он издает при посеве на питательную среду, а также пигменту из группы каротиноидов, придающему колониям золотой окрас.
Излюбленным местом обитания Staphylococcus aureus является носоглотка. Каждый второй житель нашей планеты является носителем бактерии и часто даже не подозревает об этом. Микроб долгое время может мирно существовать в организме человека, не причиняя ему никакого вреда. Под воздействием неблагоприятных факторов стафилококк активизируется и становится патогеном, что приводит к развитию различных заболеваний. В наибольшей степени этому подвержены дети, пожилые люди и беременные женщины, а также прочие лица с ослабленным иммунитетом.
Staphylococcus aureus – неподвижный микроорганизм шаровидной формы, способный размножаться и приобретать патогенные свойства только в организме человека. Он является возбудителем различных заболеваний у детей и взрослых: дерматологических, бронхолегочных, костно-суставных и эндоваскулярных патологий, раневых и внутрибольничных инфекций, гнойно-очаговых процессов. Стафилококковый сепсис – очень опасное и тяжело поддающееся лечению заболевание.
Staphylococcus aureus — самый опасный представитель данного рода, вызывающий гнойно-воспалительные процессы в жизненно важных органах с развитием тяжелых осложнений, которые могут привести к смерти. Именно поэтому данные микроорганизмы представляют особый интерес для современной медицины. Устойчивость стафилококка ауреус к большинству антибиотиков и дезинфицирующих средств осложняет лечение и делает профилактику инфекции малоэффективной.
Диагностика заболеваний, вызванных стафилококком ауреус, основывается на результатах микробиологического исследования кала, отделяемого носа и зева, содержимого придаточных пазух и другого биоматериала. В норме золотистый стафилококк определяться не должен. Лечение инфекции этиотропное, антибактериальное. Больным назначают антибиотики широкого спектра действия из группы тетрациклинов, фторхинолонов, пенициллинов, макролидов. При выявлении Staphylococcus aureus необходимо приложить максимум усилий, чтобы его ликвидировать и избежать развития опасных для жизни осложнений.
Этиология
Staphylococcus aureus — основной представитель рода Staphylococcus семейства Micrococcaceae.
Staphylococcus aureus под микроскопом
Морфология. Staphylococcus aureus – шаровидная бактерия, лишенная жгутиков и способная формировать микрокапсулы, которые защищают ее от повреждения и высыхания.
Тинкториальные свойства. Стафилококки окрашиваются по Грамму в синий цвет. В мазке они располагаются хаотично, скоплениями или в виде гроздьев винограда. Культуральные свойства. Бактерии растут на питательных средах, содержащих соль, желток куриного яйца, молоко, кровь. Обычно в микробиологических лабораториях используют элективные среды — ЖСА, МЖСА и кровяной агар. Колонии золотистого стафилококка имеют желтый или кремовый оттенок благодаря пигменту-каротиноиду и радужный венчик по периферии. Биохимические свойства. Staphylococcus aureus сворачивает цитратную кроличью плазму, обладает лецитовителлазной активностью, расщепляет аэробный маннит. Физиологические свойства. Бактерии устойчивы к замораживанию, нагреванию, солнечным лучам и некоторых химикатам. Оптимальная температура для жизнедеятельности стафилококка – 30-37°C. Способность к размножению микроб сохраняет при 4-43°C. Бактерии сохраняют жизнеспособность и в более суровых условиях. Отличительное свойство стафилококка ауреус – способность выживать в растворе поваренной соли. Микроб быстро приспосабливается к воздействию антибиотиков и антисептиков. В организме здорового человека размножение стафилококка ауреус сдерживается клетками иммунной системы, лакто- и бифидобактериями. Патогенные свойства бактерии: адгезивность – прикрепление к клеткам макроорганизма, колонизация – размножение на этих клетках, инвазивность – проникновение внутрь клеток и продукция токсинов.
К факторам патогенности стафилококка ауреус относятся:
- Фибринолизин способствует проникновению микробов в кровь и развитию сепсиса.
- Гемолизины угнетают клеточный иммунитет и помогают стафилококкам выжить в очагах воспаления. Благодаря этим факторам инфекция может приобретать генерализированную форму.
- Эксфолиатин повреждает клетки кожи. Он поражает эпидермис, вызывая появление таких пузырьков, как при ожогах.
- Лейкоцитин разрушает лейкоциты — белые клетки крови.
- Энтеротоксин – ядовитое вещество, вырабатываемое стафилококками и вызывающее у человека пищевое отравление. Он провоцирует рвоту, боль в животе, диарею. Этот яд накапливается в пище и не разрушается при термической обработке.
- Коагулаза — фермент, свертывающий кровь. Плазмокоагулаза, продуцируемая Staphylococcus aureus, бывает двух видов: связанная с клеточной стенкой и свободная. Первая защищает микроб от фагоцитов, окружая барьером из свернувшейся крови, а вторая образует коагулазотромбин, вызывающий тромбообразование.
- Белок А, выделенный с поверхности клеточной стенки стафилококка ауреус, хорошо связывает иммуноглобулины класса G.
- Пенициллиназа защищает микроб от большинства пенициллиновых антибиотиков.
- Лидаза расплавляет кожные покровы и потовые железы, позволяя бактериям проникнуть вглубь организма.
- Эндотоксин, вырабатываемый микробом, приводит к развитию интоксикационного синдрома.
Устойчивость микробов к антибактериальным препаратам – проблема современной медицины. Отдельные штаммы Staphylococcus aureus приобретают резистентность к некоторым антибиотикам – цефалоспоринам и пенициллинам. Их называют метициллин-резистентными (MRSA). Антибиотикорезистентность обусловлена мутацией штаммов, произошедшей под давлением естественного отбора и наличием у стафилококка ауреус пенициллиназы — фермента, расщепляющего молекулу пенициллина. Метициллинрезистентные стафилококки очень важны в эпидемиологическом отношении.
Эпидемиология
Стафилококк ауреус — естественный обитатель кожи и слизистых оболочек практически всех людей. В настоящее время около 50% жителей нашей планеты являются носителями бактерии. Этот условно-патогенный микроорганизм колонизирует гортань, подмышечные впадины, пах, влагалище, промежность, ЖКТ, волосистую часть головы. У большинства людей золотистый стафилококк постоянно или эпизодически обитает в носу. У 100% он живет и размножается на коже. Лица с активно функционирующей иммунной системой надежно защищены от стафилококковой инфекции. Процесс размножения Staphylococcus aureus и приобретения патогенных свойств подавляется нормальной микрофлорой макроорганизма. При снижении общей резистентности и ослаблении защитных сил микроб вызывает различные заболевания.
Патогенные штаммы Staphylococcus aureus могут проникать в организм извне при ослаблении иммунитета и контакте с бактерионосителем.
Факторы, способствующие снижению иммунитета и заражению стафилококком ауреус:
- Длительный прием антибиотиков и гормонов;
- Стрессовое воздействие;
- Недостаток витаминов и минералов в организме;
- Дисбиоз кишечника;
- Вирусная инфекция;
- Несоблюдение правил личной гигиены;
- Нарушение обмена веществ;
- Преклонный возраст;
- Недоношенность.
При нормальном иммунитете и отсутствии провоцирующих факторов бактерии не наносят вреда человеку.
Стафилококк ауреус — возбудитель внутрибольничной инфекции. Он представляет особую опасность для новорожденных детей. В роддоме и других отделениях стационара высокая концентрация данного микроба в окружающей среде связана с нарушением правил асептики и стерилизации инструментария, а также с носительством стафилококка среди медперсонала. Около 30% госпитализированных больных становятся носителями больничных штаммов S. aureus. Инфекция развивается в результате инвазивных диагностических или лечебных манипуляций, длительного приема антибиотиков, внепочечного очищения крови. Примерно 35% медицинских работников являются хроническими носителями стафилококка ауреус.
Заразиться Staphylococcus aureus также можно в салонах тату и пирсинга, где работники не соблюдают гигиенические привила и санитарные нормы.
Источником и резервуаром инфекции являются больные, носители и обсемененные продукты питания.
Способы распространения стафилококков:
- Контактный – при соприкосновении раны с патогенной поверхностью: грязью, пылью, а также при поцелуе, объятии, рукопожатии, прикосновении.
- Артифициальный — при использовании нестерильного медицинского инструментария во время диагностических инвазивных процедур.
- Аэрогенный — при разговоре, чихании, кашле.
- Пищевой — при употреблении инфицированных продуктов питания.
- Вертикальный — во время родов от матери к ребенку.
Тяжесть заболеваний, вызванных Staphylococcus aureus, зависит от вида бактерии, пораженного органа, массивности заражения, статуса иммунной системы человека.
Симптоматика
Бактерии, преодолевая «защиту» организма, становятся болезнетворными и вызывают развитие патологического процесса в той части тела, где их концентрация максимальна. Способность Staphylococcus aureus поражать различные органы и ткани человеческого организма называется полиорганным тропизмом. Микроб из первичного очага с током крови разносится по всему организму, попадая во внутренние органы и поражая их.
Общие симптомы стафилококковой инфекции — признаки интоксикационного синдрома:
- Лихорадка,
- Озноб,
- Плохое самочувствие,
- Слабость, вялость, разбитость,
- Снижение аппетита, тошнота,
- Цефалгия,
- Снижение давления,
- Нарушение сна.
Гнойное воспаление — основной признак деятельности стафилококка ауреус на коже и во внутренних органах. Стафилококковая инфекция может протекать в генерализованной или локальной форме. К первой относят сепсис, септикопиемию и септикоцемию, а ко второй – заболевания кожи, слизистых оболочек, внутренних органов, костей и суставов, ЦНС. Генерализация процесса обусловлена распространением микробов по сосудистому руслу в органы – печень, легкие, кости, почки с образованием очагов инфекции. Болезни сопровождаются интоксикацией, болью, дисфункцией органов. В отдельную группу выделяют пищевые отравления стафилококковым эндотоксином.
- Поражение кожи и клетчатки протекает по типу фурункулеза, пиодермии, панариция, флегмоны, экземы, эпидемической пузырчатки, импетиго, везикулопустулеза, эксфолиативного дерматита.
- При поражении глаз развивается хронический конъюнктивит, проявляющийся непереносимостью яркого света, слезотечением, отечностью век, выделением гноя из глаз.
фото: гнойное воспаление глаз, кожи
Диагностика
Диагностика заболеваний, вызванных стафилококком ауреус, заключается в проведении лабораторных исследований — микробиологического, серологического и общеклинического.
- Бактериологическое исследование биоматериала — посев на питательные среды с последующей идентификацией выделенного возбудителя и определения его чувствительности к антибиотикам. Материалом для исследования является: отделяемое слизистой носа, зева, влагалища, конъюнктивы, нативнй кал, рвотные массы, промывные воды желудка, отделяемое раны или некротизированные корочки, мокрота, моча, желчь, ликвор, кровь. Посев производят на элективные для S. aureus среды – кровяной агар, ЖСА, МЖСА. Чашки инкубируют в термостате в течение 48 часов, а затем описывают характер выросших колоний. Они имеют характерный кремовый или желтый цвет и радужную оболочку вокруг. Проводят микроскопию окрашенных по Грамму мазков. Изучают морфологические и тинкториальные свойства, ставят дополнительные тесты. Положительный коагулазный тест в пробирке — один из признаков, подтверждающих принадлежность возбудителя к виду S. aureus. Микробы ферментируют аэробный маннит. При этом цвет среды изменяется и становится вместо зеленого желтым. С целью определения массивности обсеменения проводят количественный анализ. Биоматериал засевают на ЖСА, подсчитывают число характерных колоний и определяют значение колониеобразующих единиц. В норме у здорового человека количество Staphylococcus aureus не должно превышать 10 3 степени. Если показатели превышают 10 6 степени, это говорит о высокой интенсивности инфицирования.
- Серологические методы исследования применяют в тех случаях, когда бактериологические анализы невозможно выполнить. Они предназначены для видовой и штаммовой идентификации возбудителя и заключаются в обнаружении в плазме крови антигенов, присущих стафилококку ауреус. Обычно ставят реакцию латекс-агглютинации, иммуноферментный анализ, реакцию пассивной гемагглютинации.
- Общеклинический анализ крови – лейкоцитоз, нейтрофилез, подъем СОЭ.
- Общий анализ мочи — протеинурия, лейкоцитурия, бактериурия.
- Фаготипирование выделенных стафилококков — определение чувствительности микроба к фагам-вирусам для назначения соответствующего лечения.
- ПЦР-диагностика – определение возбудителя заболевания по ДНК.
Лечение
Лечением стафилококка ауреус занимаются специалисты разного профиля – хирурги, дерматологи, ЛОРы, офтальмологи, терапевты, педиатры и инфекционисты.
Больным показана этиотропная противомикробная терапия.
- Если КОЕ превышает 10 3 степени, считается, что бактерии из носоглотки активно попадают в окружающую среду. Таким бактерионосителям показана санация очагов инфекции.
- При более низком значение КОЕ и отсутствие явной клиники принимать антибиотики не следует.
- Если КОЕ превышает 10 4 степени, проводят стандартное лечение антибиотиками.
- Количество микробов 10 5 степени и 10 6 степени — показатель массивного заражения стафилококком Заболевание сопровождается выраженной клиникой и требует обязательного лечения противомикробными средствами.
Антибактериальные препараты назначают на основании тестов на чувствительность возбудителя. Обычно применяют полусинтетические пенициллины «Амоксиклав», «Амоксициллин», макролиды «Эритромицин», «Азитромицин», «Кларитромицин», фторхинолоны «Ципрофлоксацин», «Офлоксацин», цефалоспорины «Цефтриаксон», «Цефотаксим», а также «Ванкомицин».
В тяжелых случаях, когда антибактериальное лечение неэффективно, применяют альтернативные и безопасные средства – антистафилококковый бактериофаг, антистафилококковую плазму и иммуноглобулин.
Местное лечение кожных заболеваний, вызванных стафилококком ауреус: обработка ран растворами антисептиков, применение антибактериальных мазей. Абсцессы и флегмоны вскрывают хирургическим путем с целью оттока гноя.
Стафилококковая пищевая токсикоинфекция лечится антистафилококковым анатоксином. Больным промывают желудок, проводят инфузионную дезинтоксикационную терапию — вводят внутривенно солевые растворы.
Всем пациентам показана симптоматическая терапия, при которой выбор препаратов определяется локализацией очага поражения и клиническими проявлениями. Иммуномодулирующее лечение ускоряет процесс выздоровления. Больным назначают «Полиоксидоний», «Ликопид», «Бронхомунал». Антигистаминные препараты используют для снятия отека со слизистой и устранения других реакций раздражения – «Супрастин», «Диазолин», «Тавегил».
Народные средства, применяемые для лечения патологий, обусловленных Staphylococcus aureus: растительные иммуномодуляторы – экстракт элеутерококка, лимонника, женьшеня; иммуностимуляторы — эхинацея, шиповник, зверобой, боярышник. Из перечисленных растений готовят настои и отвары для приема внутрь.
При отсутствии своевременного и адекватного лечения инфекции, вызванной S. aureus, развиваются тяжелые осложнения:
- Сепсис,
- Менингит,
- Эндокардит,
- Инфекционно-токсический шок,
- Кома,
- Летальный исход.
Прогноз заболевания неоднозначный. Он определяется степенью тяжести патологии. Легкие формы с вовлечением в патологический процесс кожи и слизистых полностью излечиваются без негативных последствий. Сепсис, поражение мозга и прочие тяжелые осложнения нередко заканчиваются смертью.
Видео: как легче убить золотистый стафилококк? – Доктор Комаровский
Профилактика
Мероприятия, позволяющие избежать развития стафилококковой инфекции:
- Укрепление иммунитета — закаливание, спорт, правильное питание, полноценный сон, прогулки на свежем воздухе,
- Своевременное лечение инфекционных заболеваний и санация очагов инфекции — кариеса, тонзиллита, уретрита,
- Соблюдение правил гигиены — частое мытье рук, влажная уборка в помещении, качественное приготовление пищи,
- Ограниченное посещение общественных мест в пик респираторных заболеваний.
Профилактические мероприятия государственного масштаба заключаются в постоянном контроле санитарно-эпидемиологического режима в ЛПУ, плановом обследовании медработников роддомов и хирургических отделений, своевременном выявлении носителей стафилококка ауреус, иммунизации лиц из группы риска анатоксином или иммуноглобулином.
Заболевания, вызванные Staphylococcus aureus, без соответствующего лечения быстро прогрессируют. Воспалительный процесс при этом легко переходит из первичного очага на соседние органы и ткани. В ослабленном организме может произойти инфицирование любого органа. Самолечение и нежелание обращаться за медицинской помощью к врачу обычно заканчивается осложнениями и даже смертью больных.
Видео: золотистый стафилококк в программе о “Самом главном!”
В мире, помимо животных и растений, обитает масса микроорганизмов, которые могут быть полезными или вредными для человека. Это бактерии и вирусы. И если говорить об одном из наиболее сложных в лечении и, соответственно, опасном виде, то это золотистый стафилококк, по латыни – Staphylococcus aureus.
Общая информация о золотистом стафилококке
Что это? Бактерия, относящаяся к классу анаэробных, то есть, способных жить без воздуха, неподвижная, Грам-положительная. Существует немало типов стафилококка, но именно золотистый наиболее опасный. Назвали его так не из-за цвета. Ауреус – потому что при посеве в питательную среду колония бактерий дает желто-золотистое окрашивание.
Сразу можно подумать, что микроорганизм редко встречается, но на самом деле, его можно обнаружить везде. Бактерия живет на коже и слизистых человека, прекрасно себя чувствует в окружающей среде: на мебели, игрушках, посуде, деньгах. Это объясняется высокой устойчивостью микроорганизма к антисептикам, моющим средства, даже кипячению (гибнет только через 10 минут), замораживанию. Не боится стафилококк и спирта, перекиси водорода. Единственное из доступных средств, которое может убить бактерию – обычная «Зеленка». Чаще всего обнаруживается золотистый стафилококк в носу.
Впрочем, несмотря на распространенность, этот микроорганизм вызывает заболевания редко, даже живя на теле человека. Для того чтобы развилось воспаление, необходимо снижение иммунитета. Только в этом случае бактерии начнут активную деятельность и вызовут самые разные болезни кожи и слизистых.
Опасность золотистого стафилококка в том, что он устойчив к пенициллиновым антибиотикам за счет выработки лидазы и пенициллиназы – ферментов, разрушающих белки. Эти же вещества расплавляют кожу и слизистые, помогая бактериям проникнуть в организм.
Кроме того, стафилококк вырабатывает эндотоксин, вызывающий у человека интоксикацию, пищевое отравление и инфекционно-токсический шок – опасное состояние, которое крайне сложно поддается лечению.
Стоит прибавить к этому отсутствие постоянного иммунитета к таким бактериям. То есть, переболев инфекцией, человек все так же рискует заболеть вновь.
Норма показателей золотистого стафилококка
Как уже было сказано выше, бактерия есть везде. Но если был обнаружен стафилококк, это еще не повод для паники, есть определенные нормы содержания его на коже, слизистых, предметах. Многие начинают переживать, получив результаты анализа: стафилококк золотистый 10 в 4, или, к примеру, золотистый стафилококк 10 в 3. Чтобы разобраться, нужно понимать принципы определения количества микроорганизмов в биоматериале.
Существует 4 степени роста бактерий:
- – слабый рост;
- – рост до 10 колоний одного вида;
- – рост от 10 до 100 колоний;
- – рост больше 100 колоний;
Понятно, что чем больше степень, тем выше количество бактерий, соответственно, активнее патологический процесс. Первые две степени говорят о присутствии бактерии в биоматериале, третья – о том, что началась болезнь, стафилококк 4 степени – это уже выраженная патология.
Как расшифровать данные посева? Для каждого органа есть свои нормы. Так, золотистый стафилококк 10 в 6 степени – верхняя граница нормы. Обнаруживаемый микроорганизм в носу, зеве или горле, посевах кала пока еще не несет опасности. То есть, если анализы показывают золотистый стафилококк 10 в 5 степени или ниже, причин для особой паники нет. Возможно, потребуется лечение, но в каждом конкретном случае решает врач, учитывая многие нюансы. Конечно же, чем меньше цифра, тем лучше, но если обнаруживается стафилококк 10 в 3 степени, это вариант нормы.
Факторы риска
Чтобы активизировался золотистый стафилококк, причины должны быть вескими, так как иммунитет сам по себе не снижается. Провоцирующими факторами являются такие состояния:
- гиповитаминоз, авитаминоз;
- нарушения в питании;
- другие инфекционные болезни;
- прием антибиотиков;
- прием гормональных препаратов;
- дисбактериоз.
Это причины, провоцирующие развитие инфекции у взрослых и у детей старше года. Но чаще всего обнаруживается стафилококк у грудничка. Более того, самый высокий риск заполучить стафилококка – у новорожденных, так как в больнице (и роддом не исключение) всегда выявляется большое количество золотистого стафилококка, что неудивительно, учитывая стойкость бактерии к антисептикам.
Если же новорожденный появился раньше срока или родился незрелым, то вероятность инфицирования еще больше повышается. Относительно эффективной профилактикой этого является раннее прикладывание к груди и отказ от искусственного вскармливания.
Какие заболевания могут возникнуть
Как у взрослых, так и у детей независимо от возраста золотистые стафилококки вызывают множество заболеваний. Инфекция поражает кожу и слизистые, но может попадать в ранку, внутренние органы.
Характерные для всех типов инфицирования симптомы золотистого стафилококка: повышенная температура и выраженная интоксикация, которая проявляется слабостью, плохим аппетитом, тошнотой. То есть, если возникло воспаление на коже, даже небольшое, но оно сопровождается высокой температурой и явным ухудшением самочувствия, можно заподозрить стафилококковую инфекцию.
Кожные болезни
Они наиболее часто встречаются, ведь бактерии живут на коже, и при снижении иммунитета именно покровы тела становятся главной мишенью, тем более, если имеется ранка, какие-либо высыпания и так далее. Бактерия может вызвать такие патологии:
Флегмоной называют гнойный процесс, который развивается в жировой клетчатке, и чаще всего он запускается именно из-за золотистого стафилококка. Помимо общих симптомов, появляется припухлость и болезненность пораженной области. Флегмоны не имеют четких границ, и без лечения могут перейти на другие ткани: мышцы, кости и так далее. Кроме того, возможно развитие сепсиса.
Абсцесс – другое гнойное заболевание мышц или жировой клетчатки, но с четкими границами и инфильтративной капсулой, за счет чего несколько снижается опасность заболевания.
Фурункулы тоже признаки золотистого стафилококка. Так, гнойное воспаление волосяного фолликула чаще всего развивается из-за этой бактерии. Если же фурункулов много, и они сливаются, такое состояние называют карбункулом.
Болезни суставов и костей
В этом случае золотистый стафилококк симптомы дает и общие, и местные. Среди последних боль в мышцах и суставах, которая обостряется и усиливается при движении. Над местом воспаления краснеет кожа, образуется припухлость.
Как правило, инфекция проникает в кость через рану при переломе, после оперативного вмешательства. Попав в ткани, бактерия расплавляет их, поэтому легко доходит до костного мозга, вызывая остеомиелит, возможно и развитие воспаления подкожной клетчатки с формированием тех же флегмоны или абсцесса.
Заболевания дыхательной системы
Тоже весьма распространённая группа. Это тот самый случай, когда смыв из зева или глотки, показывающий стафилококк 10 в 4 степени, говорит о необходимости специфического лечения, особенно если биоматериал брали у малыша, часто болеющего.
Так, если ребенок в четвертый раз подхватывает ангину, бронхит, и любая ОРВИ у него проходит с осложнениями, смыв нужно делать обязательно.
Если же ангина, бронхит появились впервые, но протекают тяжело, с высокой температурой, увеличением лимфоузлов, сильной интоксикацией, стоит подозревать стафилококковый воспалительный процесс.
Особенно опасна пневмония, вызванная этой бактерией, так как ее течение очень тяжелое, и лечить ее сложно за счет устойчивости стафилококка ко многим антибиотикам. Возникающий воспалительный процесс может даже спровоцировать появление гнойников в дыхательной системе.
Токсический шок
Причины возникновения такого состояния известны давно – и это золотистые стафилококки. Ни один другой микроорганизм не вызывает столь серьезной патологии, которая к тому же может появляться внезапно. Начинается синдром токсического шока резким повышением температуры, сильной интоксикацией: слабостью, резкой головной болью, тошнотой. Появляющийся гной из раны или каких-либо органов – один из симптомов токсического шока. Кроме того, образуется сыпь на теле, вероятно шелушение кожи.
Патологический процесс сложно поддается терапии, к тому же он развивается быстро, не всегда есть время для распознавания возбудителя. Поэтому, как правило, при такой симптоматике сразу назначают антистафилококковую терапию.
Лечение стафилококковой инфекции
Специфика терапии в том, что не всегда стоит назначать антибиотики. Так, если имеется локализованная форма или носительство (например, выявлен золотистый стафилококк 10 в 3 степени), то прием антибиотиков может даже усугубить процесс за счет уничтожения полезной микрофлоры. В такой ситуации помогает стимуляция иммунной системы, обработка покровов и слизистых зеленкой, хлорофиллиптом, прием антистафилококкового бактериофага. В зависимости от того, какие у больного симптомы, и лечение будет соответствующим. Играет важную роль и то, кто болеет: взрослый, подросток или младенец.
В тех случаях, когда процесс крайне выражен или имеет генерализированную форму, вполне оправдано назначение антибиотиков. Как правило, используются цефалоспорины, оксациллин, офлоксацин, другие препараты непенициллинового ряда. Обязательно назначается бактериофаг, иммуностимулирующие лекарства.
Что касается терапии оститов и кожных заболеваний, то она комбинированная. Чаще всего проводится хирургическая санация, после которой делают регулярную обработку полости. В то же время назначают антибиотики и иммуностимуляторы.
Таким образом, лечение болезней, вызванных золотистым стафилококком, сложное, но возможное при условии своевременного обращения за врачебной помощью.